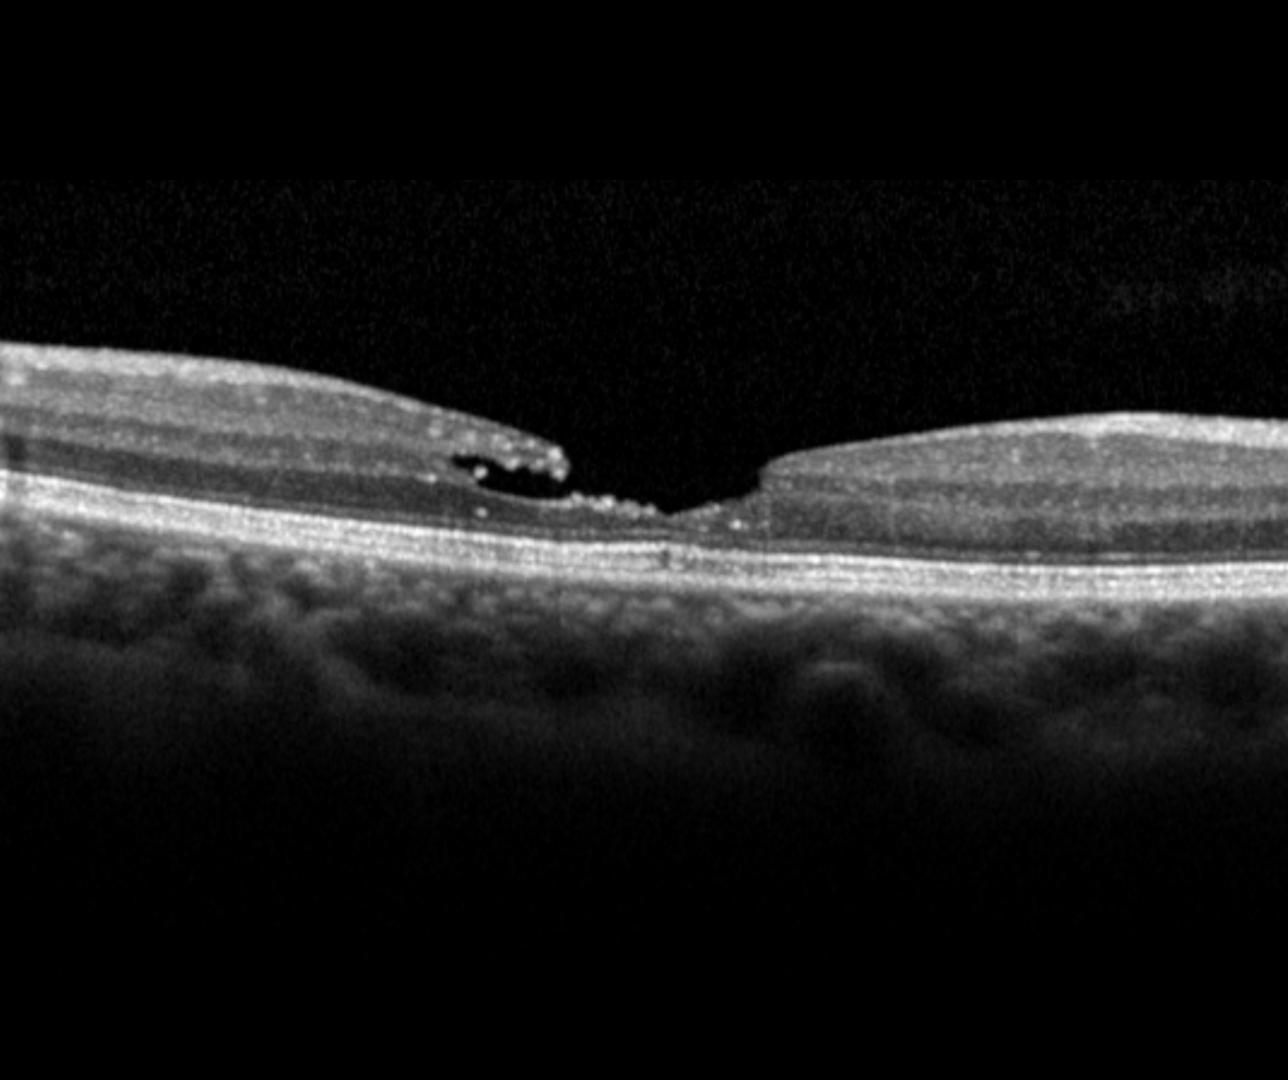

Overview
A lamellar macular hole is defined as a partial thickness foveal defect with an irregular foveal contour and separation between the retinal layers.
Clinically, it appears similar to a full thickness macular hole as a round reddish lesion at the macula.
Mandatory criteria for diagnosis include:
1) Irregular foveal contour (ie, abnormal, non-linear shape)
2) Foveal cavity with undermined edges
3) Sign evoking a loss of foveal tissue (pseudo-operculum, thinning of the fovea at its centre or around)
Other associated features may include:
1) Epiretinal proliferation
2) Foveal bump
3) Ellipsoid zone disruption
Case Examples
-
Case 1:Lamellar macular hole
A 74 year old Asian female with best corrected visual acuity in the left eye of 6/12 (20/40).
-
Case 2: Lamellar macular hole
A 51 year old Asian female with best corrected visual acuity of 6/9.5 (20/32) in the right eye.
Differential Diagnosis
References
Stalmans, P. Duker, J. Kaiser, PK. Heier, JS. Dugel, P et al. (2013) OCT-Based interpretation of the vitreomacular interface and indications for pharmacologic vitreolysis. Retina Volume 33 - Issue 10


